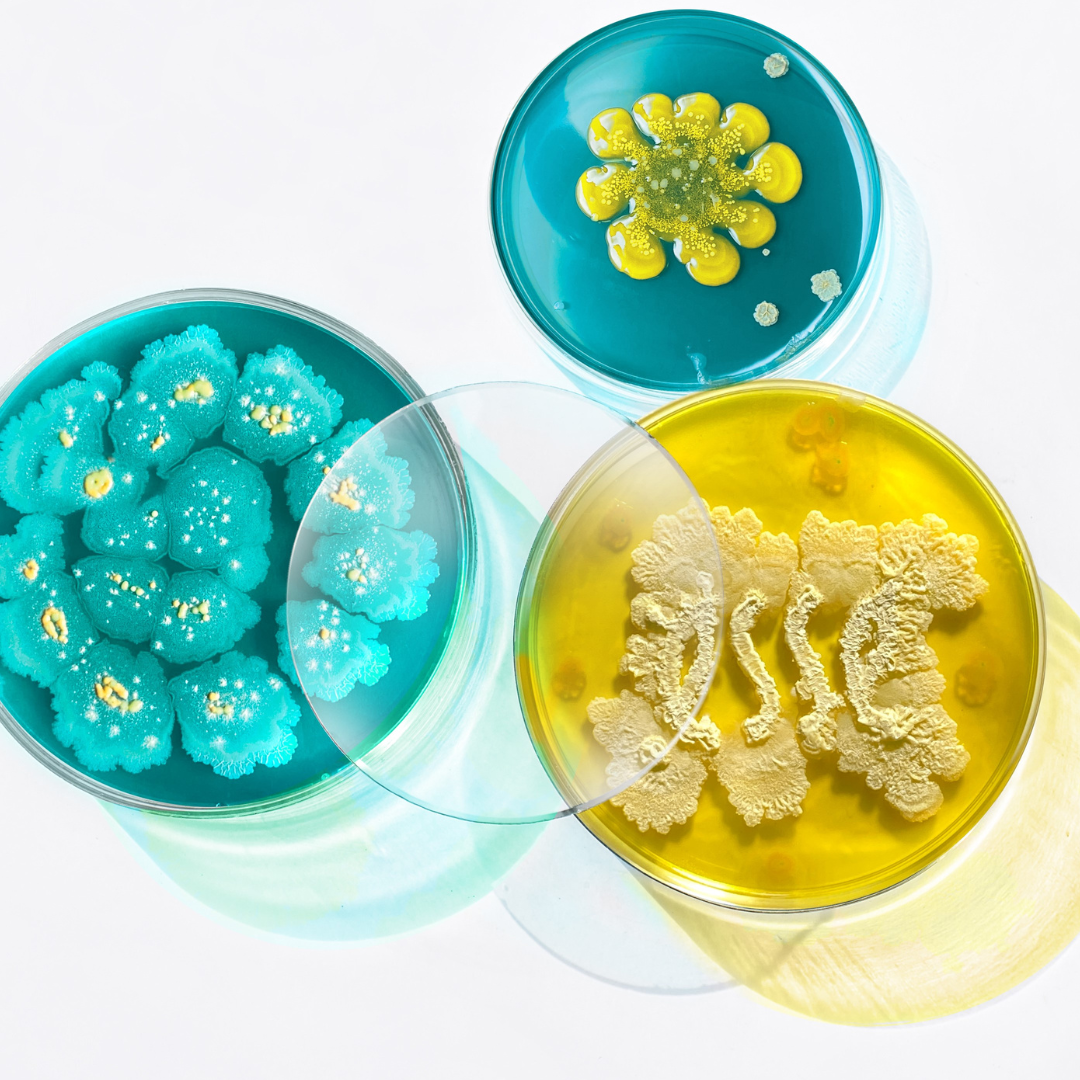

The Esse Live Probiotic Facial (75min+) £145
The Esse Live Probiotic Facial is the ultimate fusion of advanced microbiome science and therapeutic touch, designed to restore the skin to its most balanced, resilient and youthful state. Using pioneering BIOME+ formulations and a unique live probiotic mask delivering 5 billion active Lactobacillus cultures, this treatment works at the deepest biological level to recalibrate the skin. By calming chronic inflammation - a key driver of premature ageing, while strengthening the skin barrier and supporting cellular renewal, the skin is able to age more slowly, intelligently and with greater resilience. Ideal for those with mature skin, and/or sensitive, acne/rosacea/eczema prone skin, or experiencing hormonal skin changes
-
The Experience:
- Skin analysis
- Gentle, barrier-respecting cleanse using BIOME+ formulations
- Targeted exfoliation and steam (if appropriate)
- Signature 30m anti-inflammatory massage, incorporating Gua Sha
- Application of the world’s first live probiotic mask, delivering 5 billion CFUs of live Lactobacillus
- Scalp tension release massage
- Advanced probiotic, prebiotic and postbiotic serums selected for your skin’s needs
- Calming, barrier-repair moisturisation
-
Skin Benefits:
- Restores and re-wilds the skin to a healthy state of homeostasis
- Reduces inflammation, redness and reactivity
- Softens lines and wrinkles and supports healthy ageing without irritation
- Supports clearer skin and helps rebalance acne-prone conditions
- Strengthens the skin barrier and reduces transepidermal water loss
- Improves firmness, elasticity and skin resilience
- Encourages long-term skin repair rather than short-term correction
-
The Science:
This treatment features BIOME+ Level formulations, including live probiotics that can actively colonise the skin and shift microbial populations in a positive direction.
The live probiotic mask delivers 5 billion colony-forming units of live Lactobacillus, which:
- Compete with opportunistic microbes linked to acne, eczema and inflammation
- Support natural lactic acid production for improved hydration and barrier repair
- Help retrain the skin’s immune response, reducing over-reactivity and premature ageing

The ultimate LED upgrade
Medical grade Celluma LED therapy can be added to this facial. Targeted wavelengths enhance photobiomodulation within the skin, increasing cellular energy (ATP) and amplifying the signals responsible for collagen production, healing, skin renewal and skin longevity. Upgrading your facial to include a 'Celluma' LED treatment (not just any LED), will result in a more powerful, optimised outcome in terms of skin health and results
How Esse re-wilds the skin?
Esse is built on the understanding that modern skin has lost something essential. In the Western world, over-sanitisation, antibiotics, preservatives, pollution and synthetic skincare have dramatically reduced the diversity of microbes we coexist with. This loss of microbial diversity is directly linked to rising levels of acne, eczema, rosacea, sensitivity and premature ageing. By combining prebiotics (which feed beneficial microbes), postbiotics (which support barrier function and immune modulation), and live probiotics (which actively repopulate the skin), Esse skincare helps to re-wild the microbiome, teaching skin how to heal itself again
Need more detail?
Is this Facial Suitable For Me?
✅ YES – this treatment is generally suitable if:
- You have normal, dry, oily or combination skin AND/OR sensitive or acne/rosacea/eczema/dermatisis- prone skin
- You are 14+ (18+ if adding LED)
- You are pregnant or nursing
- You have cancer, and undergoing oral oncology treatment, radiotherapy or chemotherapy (please contact us if radiotherapy is in the face, neck or décolletage area to discuss current levels of sensitivity)
🚫 NO – this treatment may not be suitable if:
- You are currently taking, or have taken prescription oral retinoids such as (Isotretinoin / Roaccutane) in the last 6 months.
- You are currently applying, or have applied prescription topical retinoids (tretinoin/adapalene) in the last 2 weeks.
- You are currently applying, or have applied strong topical steroids in the treatment area in the last 4 weeks *Please contact to discuss
- You have active skin infections, cold sores, open wounds or unhealed skin in the treatment area
- You have diagnosed 'skin' cancer in the treatment area (previously treated skin cancers require medical sign-off)
- You have had recent surgery in the treatment area (please contact us to discuss)
- You have a diagnosed allergy to a particular skincare ingredient or essential oil (Esse uses pregnancy safe essential oils) please contact us to discuss
N.B Most unknown allergies are caused by artificial fragrance including 'parfum' and 'fragrance' none of which are in any of our facials
⏱ Injectables & advanced treatment guidelines
- Botox / anti-wrinkle injections: Facial treatment is suitable 2 weeks post botox injections / 2 weeks prior to your next botox injections
- Dermal fillers: Facial treatment is suitable 3 weeks post filler injections
- Chemical peels, laser treatments, deep microneedling or invasive skin procedures: Facial treatment is suitable 3 weeks post peel/laser/invasive treatment.
If you are unsure whether this facial is right for you, please contact us at hello@eleanorolsen.co or whatssap 07821 964865 and we will be happy to advise before booking.
Downtime & Aftercare
Downtime
- This is a non-invasive facial with no downtime
- Mild warmth or slight flushing may occur and typically resolves quickly
- You can return to normal activities straight after treatment
Aftercare advice
To support your skin and maximise results:
- Drink plenty of water for the rest of the day to support lymphatic drainage
- Avoid alcohol for 24 hours following treatment
- Keep skin clean, hydrated and well moisturised
- Apply SPF daily and avoid prolonged sun exposure
- Avoid heat-based activities (sauna, steam rooms, hot yoga) for 24 hours
- Avoid exfoliating acids, retinoids and strong actives for 24–48 hours
Enquiry
Please contact us at hello@eleanorolsen.co and we will be happy to advise before booking.
